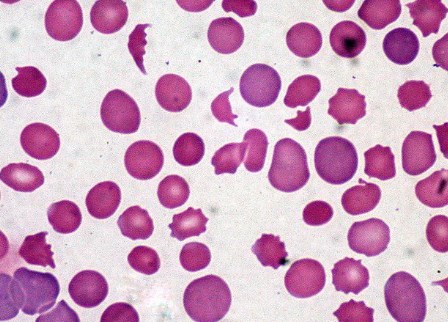
Các nhà nghiên cứu phát hiện ra các hợp chất tiêu diệt bệnh bạch cầu mới

Bổ sung vitamin B6 có thể làm giảm lo lắng và trầm cảm
Những người tham gia thử nghiệm cho biết họ cảm thấy ít lo lắng hoặc trầm cảm hơn sau khi dùng Vitamin B6 liều cao trong một tháng. Thử nghiệm cung cấp bằng chứng cho thấy tác dụng làm dịu của B6 đối...